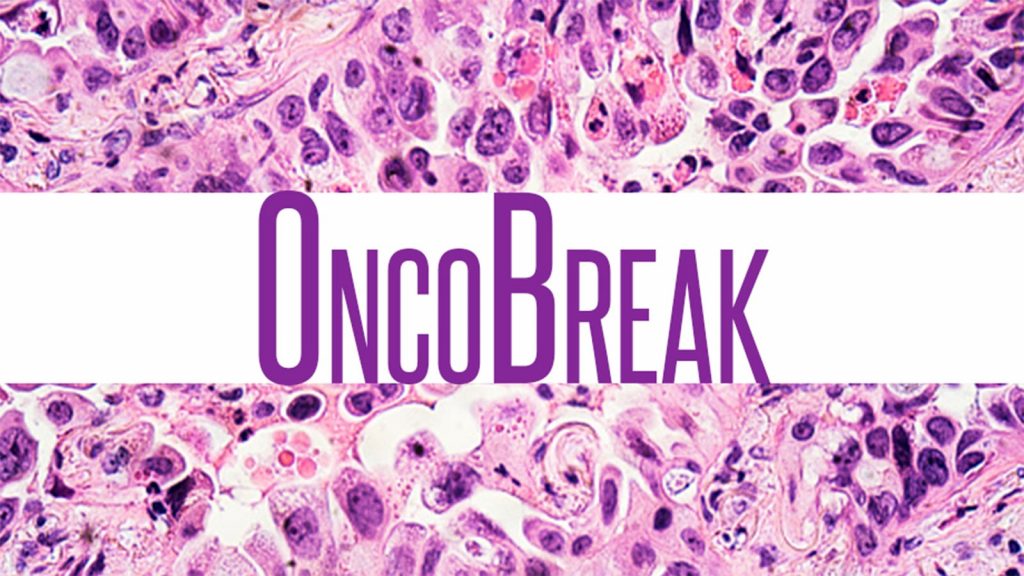
Facebook Ads Tout Unproven Therapy; Younger People Skip CRC Tests; Low-HER2 Tumors

Despite vowing to combat medical misinformation, Facebook continues to accept ads for unproven cancer treatments. (MIT Technology Review)
A federal judge denied a request by Bristol Myers Squibb (BMS) to dismiss a $6.4 billion lawsuit alleging the company intentionally delayed the CAR T-cell therapy lisocabtagene maraleucel, or liso-cel, (Breyanzi) to avoid payments to shareholders of Celgene after BMS purchased the latter. (Reuters)
Meanwhile, BMS announced expanded approval of liso-cel to include certain relapsed/refractory large B-cell lymphomas treated with at least one prior line of therapy.
Ipsen announced plans to acquire Epizyme and the first-in-class EZH2a inhibitor tazemetostat (Tazverik), which has FDA approval for certain patients with follicular lymphoma.
Younger Americans (ages 50-54) eligible for colorectal cancer screening were 30% less likely to follow screening guidelines as compared with people ages 70-75. (American Association for Cancer Research)
COVID vaccines proved to be safe for patients with lung cancer treated with immune checkpoint inhibitors, according to a study from Japan. (International Association for the Study of Lung Cancer)
The Leukemia & Lymphoma Society announced the launch of a collaborative research program aimed at expediting development and use of targeted therapies for pediatric leukemias.
Data on 5,000 patients with breast cancer suggest that HER2-low tumors are not a distinct type of breast cancer and that differences in response to treatment relate more to the presence or absence of hormone receptors. (Dana-Farber Cancer Institute, JAMA Oncology)
Failure to communicate and act on abnormal laboratory test results over a 2-year period led to a delayed cancer diagnosis for a patient at the Hampton, Virginia VA Hospital, according to the VA Office of the Inspector General. (13News Now)
Novartis announced it has resumed production and delivery of radioligand therapy after addressing issues that led to a voluntary suspension of production in May.
The Association of Community Cancer Centers (ACCC) expressed support for the Enhancing Oncology Model, which will allow ACCC members to “continue to delivery high-quality, equitable, and affordable cancer care.”
-
![author['full_name']](data:image/png;base64,R0lGODlhAQABAAD/ACwAAAAAAQABAAACADs=)
Charles Bankhead is senior editor for oncology and also covers urology, dermatology, and ophthalmology. He joined MedPage Today in 2007. Follow
![author['full_name']](https://clf1.medpagetoday.com/media/images/author/charlesBankhead_188.jpg)